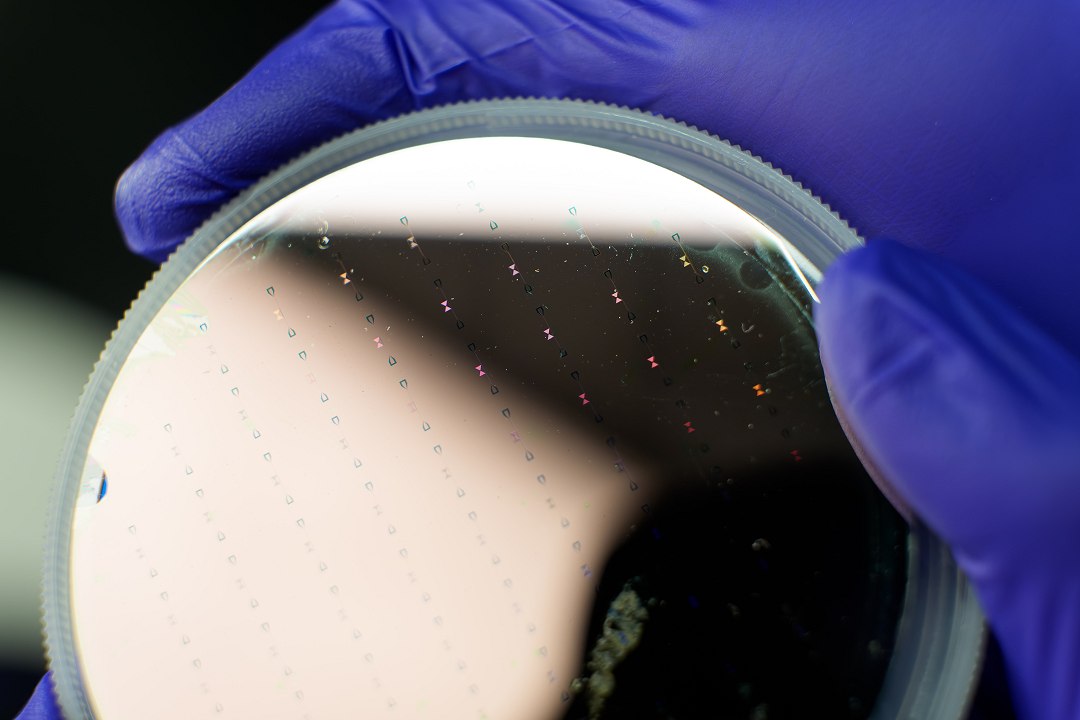

Uma inovação na fabricação de bits quânticos mais resistentes significa que agora as redes quânticas estão prestes a se tornar viáveis em nível nacional.
Fonte
Artigos Recentes
Artigos relacionados
Mundo
EUA volta a atacar o Irã; “Agressão injustificada e contínua”
Os Estados Unidos realizaram novos ataques em território iraniano, em retaliação à...
Byadminjunho 10, 2026
Mundo
stf julgamento recursos big techs
“Fomos muito equilibrados ao estabelecer essa tese”, disse Toffoli. “Não se trata...
Byadminjunho 10, 2026
Mundo
Fim de caça franco-alemão expõe limites da defesa na Europa
IGOR GIELOWVIENA, ÁUSTRIA (FOLHAPRESS) – França e Alemanha cancelaram um programa para...
Byadminjunho 10, 2026
Mundo
Nasa defende tripulação da missão Artemis 3, formada apenas por homens
A terceira fase do programa Artemis 3 consistirá em testar a espaçonave...
Byadminjunho 10, 2026

Deixe um comentário